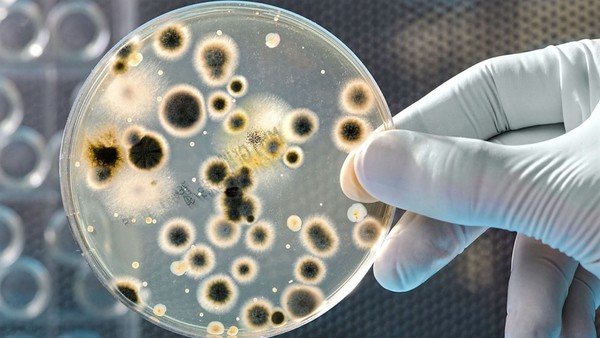

Resistencia a los antibióticos puede ser la causante de la próxima pandemia
Redacción. La Asociación Colombiana de Infectología (ACIN) hace un llamado a la opinión pública sobre el uso adecuado de los antibióticos, más aún, cuando se está en una temporada invernal y pico respiratorio, donde se incrementa el uso de estos medicamentos para el manejo de estas infecciones, que, en la mayoría de los casos, son de origen viral, es decir, que no requieren administrar antibióticos.
Antes de que iniciará la pandemia del Covid-19, la OMS ya había alertado a la población mundial sobre la grave situación que se avecina, si no se toman las medidas de prevención pertinentes, para evitar que la próxima pandemia sea por bacterias que no se pueda combatir, debido a su multirresistencia a los antibióticos existentes.

Según un reciente estudio publicado en The Lancet Microbe ,una de las publicaciones más relevantes sobre investigación microbiana en el mundo, asegura que precisamente debido a la pandemia por el Covid-19 aumentó el número de hospitalizaciones y en consecuencia también lo hizo la cantidad de pacientes con un cuadro combinado: una función inmunológica deteriorada por el SARS-Cov2 y la infección por bacterias multirresistentes a antibióticos. Muchas veces el paciente se recupera de Covid-19, pero puede tener complicaciones o incluso morir como consecuencia de la infección provocada por estas bacterias.

José Millán Oñate, Presidente Asociación Colombiana de Infectología ACIN.
Y es que, aunque se ha hablado bastante del tema, de acuerdo con cifras del Ministerio de Salud, incluidas en el Plan de Respuesta Nacional a la Resistencia a los Antimicrobianos, a pesar de la expresa prohibición de la venta de medicamentos como los antimicrobianos sin la presentación de la fórmula médica, estos productos aún pueden ser adquiridos sin prescripción en el territorio nacional. El estudio encontró que en Bogotá en el 80% de las farmacias muestreadas era posible adquirir los antibióticos sin presentar fórmula médica alguna.
“En este sentido la responsabilidad es de todos, tanto de los entes gubernamentales en cuanto a la legislación y la generación de políticas a nivel nacional; como de los médicos prescriptores quienes deben medicar antibióticos cuando sea estrictamente necesario”, resalta el doctor José Millán Oñate Gutiérrez, Presidente Asociación Colombiana de Infectología ACIN.

Agregó que el médico debe explicarle al paciente la importancia de tomar la dosis formuladas en el tiempo indicado (actualmente el índice de abandono de la terapia es del 81%), facilitando el tratamiento prescribiendo concentraciones que favorecen la adherencia al disminuir el número de dosis diarias.
Aseguró que es responsabilidad también de las farmacias, al exigir la fórmula médica para la venta de antimicrobianos y de abstenerse de ‘formular’ o sugerir este tipo de medicamentos; y de la comunidad en general no interrumpiendo ni aumentando el tratamiento indicado, ni automedicándose.

Según la OMS, es necesario que se cambie urgentemente la forma de prescribir y utilizar los antibióticos. Aunque se desarrollen nuevos medicamentos, si no se modifican los comportamientos actuales, la resistencia a los antibióticos seguirá representando una grave amenaza.
Los cambios de comportamiento también deben incluir medidas destinadas a reducir la propagación de las infecciones, a través de la vacunación, el lavado de las manos, la seguridad de las relaciones sexuales y una buena higiene alimentaria.
“Los antibióticos son medicamentos de uso restringido, por eso deben ser formulados por el médico tratante. Tienen efectos secundarios, que pueden provocar graves problemas en la salud del paciente que los consuma deliberadamente, como por ejemplo intoxicación, falta de efectividad, enmascaramiento de síntomas que pueden dificultar el tratamiento y en algunos casos adicción, sin contar con el más grave: la resistencia bacteriana, que crea ‘súper bacterias’ que se vuelven inmunes a los tratamientos, permitiendo que se generen enfermedades que no puedan ser manejadas y que pueden provocar la muerte del paciente”, afirma el doctor José Millán Oñate Gutiérrez, Presidente Asociación Colombiana de Infectología ACIN.
Según la OMS, el costo de la Resistencia a los Antimicrobianos (RAM) para la economía es considerable. Además de muerte y discapacidad, la prolongación de las enfermedades se traduce en estancias hospitalarias más largas, la necesidad de medicamentos más caros y dificultades financieras para las personas afectadas.

Conscientes de la responsabilidad social que tiene frente al tema, la Asociación Colombiana de Infectología brindó su asesoría al Ministerio de Salud y al Instituto Nacional de Salud, quienes en conjunto generaron una serie de recomendaciones denominadas los 12 Mandamientos para evitar la resistencia antimicrobiana.
Los 12 mandamientos para evitar la resistencia antimicrobiana
- Sólo tome antibiótico si su médico lo recetó: Nada sustituye la consulta con un médico ya que solo él puede conocer a profundidad cómo funciona su cuerpo frente a los microrganismos.

- Automedicarse antibióticos puede tener riesgos para su salud: Tomarlos en momentos innecesarios puede crearle a futuro, mayores complicaciones en el tratamiento de enfermedades. Hacerlo sin prescripción médica puede resultar perjudicial, tanto para la propia salud como para la de los demás.
3. Tome el antibiótico como se lo recetaron y por el tiempo indicado: Los medicamentos están diseñados para tratar enfermedades específicas, su médico conoce a profundidad cuál es el medicamento que será más efectivo para tratar su enfermedad. La comunidad científica insiste en la necesidad de ser rigurosos a la hora de consumirlos, pues su mal uso está haciendo que estos medicamentos pierdan eficacia.

- Aumentar la dosis de antibiótico no lo mejora más rápido, pero en cambio aumenta el riesgo de efectos secundarios: Ampliar la dosis de un medicamento puede generarle una intoxicación y tener un efecto adverso en su organismo.
5. Si los síntomas de la infección persisten no prolongue el antibiótico, consulte a su médico: Prolongar la medicación no ayudará con el tratamiento de los síntomas ya que puede que su enfermedad necesite un seguimiento distinto a la inicial. Consulte al profesional, pues en algunos casos se hace necesaria una segunda revisión médica.

- Los antibióticos solo sirven para infecciones causadas por bacterias: Aunque en ocasiones las manifestaciones clínicas de las infecciones producidas por diferentes microorganismos pueden ser similares, es clave realizar un diagnóstico que nos permita utilizar el fármaco adecuado; el antibiótico solo sirve para las infecciones causadas por bacterias.
7. Los antibióticos no sirven para curar infecciones causadas por virus como el de la gripa: Los antibióticos son fármacos que se utilizan para combatir las infecciones causadas por bacterias, no tienen ningún efecto en contra de los virus.

- Los antibióticos no previenen el contagio de la gripa ni de otros virus: El resfriado y la gripe, tan habituales en épocas de lluvia, son enfermedades causadas por virus, por lo que los antibióticos no son efectivos para tratarlas.
9. No comparta antibióticos con familiares o amigos: Es frecuente que una persona que se siente mal, con dolor de garganta, molestias urinarias o fiebre, recurra a esas pastillas de antibiótico que le sobraron de un tratamiento previo, propio o de algún familiar. ¡No lo haga!

- No administre sus antibióticos a sus mascotas, ellos requieren ser vistos por el veterinario en caso de necesitarlos: La Organización Mundial de la Salud (OMS) recomienda que las industrias agropecuarias, piscicultora y alimentaria dejen de utilizar sistemáticamente antibióticos para estimular el crecimiento y prevenir enfermedades en animales sanos. En algunos países, al rededor del 80% del consumo total de antibióticos de importancia médica se da en el sector animal, principalmente para estimular el crecimiento en animales.
11. El mal uso de los antibióticos ocasiona bacterias más resistentes: La resistencia a los antibióticos hace que se prolonguen las estancias hospitalarias, que se incrementen los costos médicos y que aumente la mortalidad.
12. El lavado de manos frecuente evita el contagio de virus y bacterias: Según la OMS el lavado de manos es una de las estrategias claves para una vida saludable. Evita la propagación de infecciones respiratorias, diarreicas, hepatitis A y gastroenteritis, entre otras.
“Según la Organización Mundial de la Salud (OMS), si no se toman medidas ya, en 2050 prácticamente la totalidad de los antibióticos serán ineficaces para prevenir y tratar enfermedades humanas. Es así, como el llamado es a la prevención, pues la disminución de la resistencia bacteriana es responsabilidad de todos”, concluye el doctor Oñate Gutiérrez, presidente ACIN.













